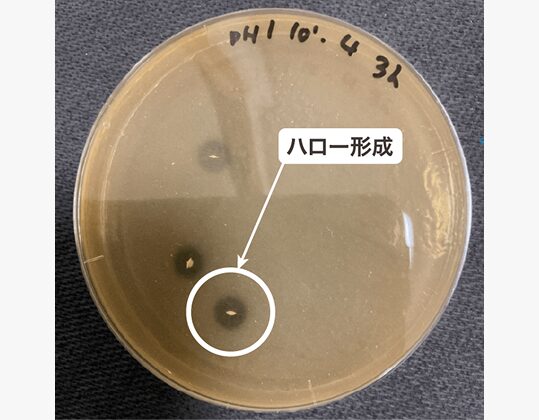

\ Good Point 1 /
土壌細菌群の「菌の多様性」に着目

植物の根が土壌菌と支え合うように、私たちの腸もまた、菌との共生で成り立っています。
豊かな土壌が多様な微生物に守られているように、健やかな体にも「多様性」が欠かせません。
SOIL cureは、この自然界の循環に着目して生まれた、プロバイオティクスサプリメントです。
\ Good Point 2 /
「短鎖脂肪酸生産菌群」が生きて腸まで届く

① 有用菌群(短鎖脂肪酸生産菌群)が生きて腸まで届く
SOIL cureは、人工胃液・人工腸液での生残性試験を実施済み。
土壌由来の有用菌群が胃酸や腸液にさらされても死滅しにくいことが試験で確認されています。
「生きて届く菌」として、プロバイオティクスの基準をしっかりとクリアしたサプリメントです。
※pH1.0(空腹時相当)の人工胃液に1時間さらされても43.7%が生存、
3時間後でも3.1%が生き残ることを確認。
② 今注目の「短鎖脂肪酸」を作り出す菌を含有
含まれる有用菌群が腸内で増殖する過程で、酢酸・プロピオン酸・吉草酸などの
短鎖脂肪酸を産生することが判明しています。
※ハロー形成(コロニー周囲の透明な輪)がその証拠です。
※人工腸液(3時間培養)でも短鎖脂肪酸産生菌の生存が確認されています。
\ 今注目の健康サポート物質「短鎖脂肪酸」って? /

\ Good Point 3 /
1日分(1粒200mg)のカロリーは約0.9kcalだから、
糖質制限中の方も安心!

1日の摂取目安量(一粒200mg)のカロリーはわずか0.9kcal。
糖質制限中の方や、カロリーが気になる方でも、毎日気軽に続けられます!
\ Good Point 4 /
素材がシンプル♪(※1)賦型剤(※2)・保存料不使用
※1:各商品の原材料は商品ページに記載しています。
※2:サプリメントを製造する際に成形型等の目的で使用される添加物のこと

商品の詳細はこちらからチェック!
\ 一日の菌活をお手軽に! /

\ プレバイオティクス素材をプラス /

\ ヘビーユーザーはこちらがオトク /

\ まずは1週間試してみたい方に /

